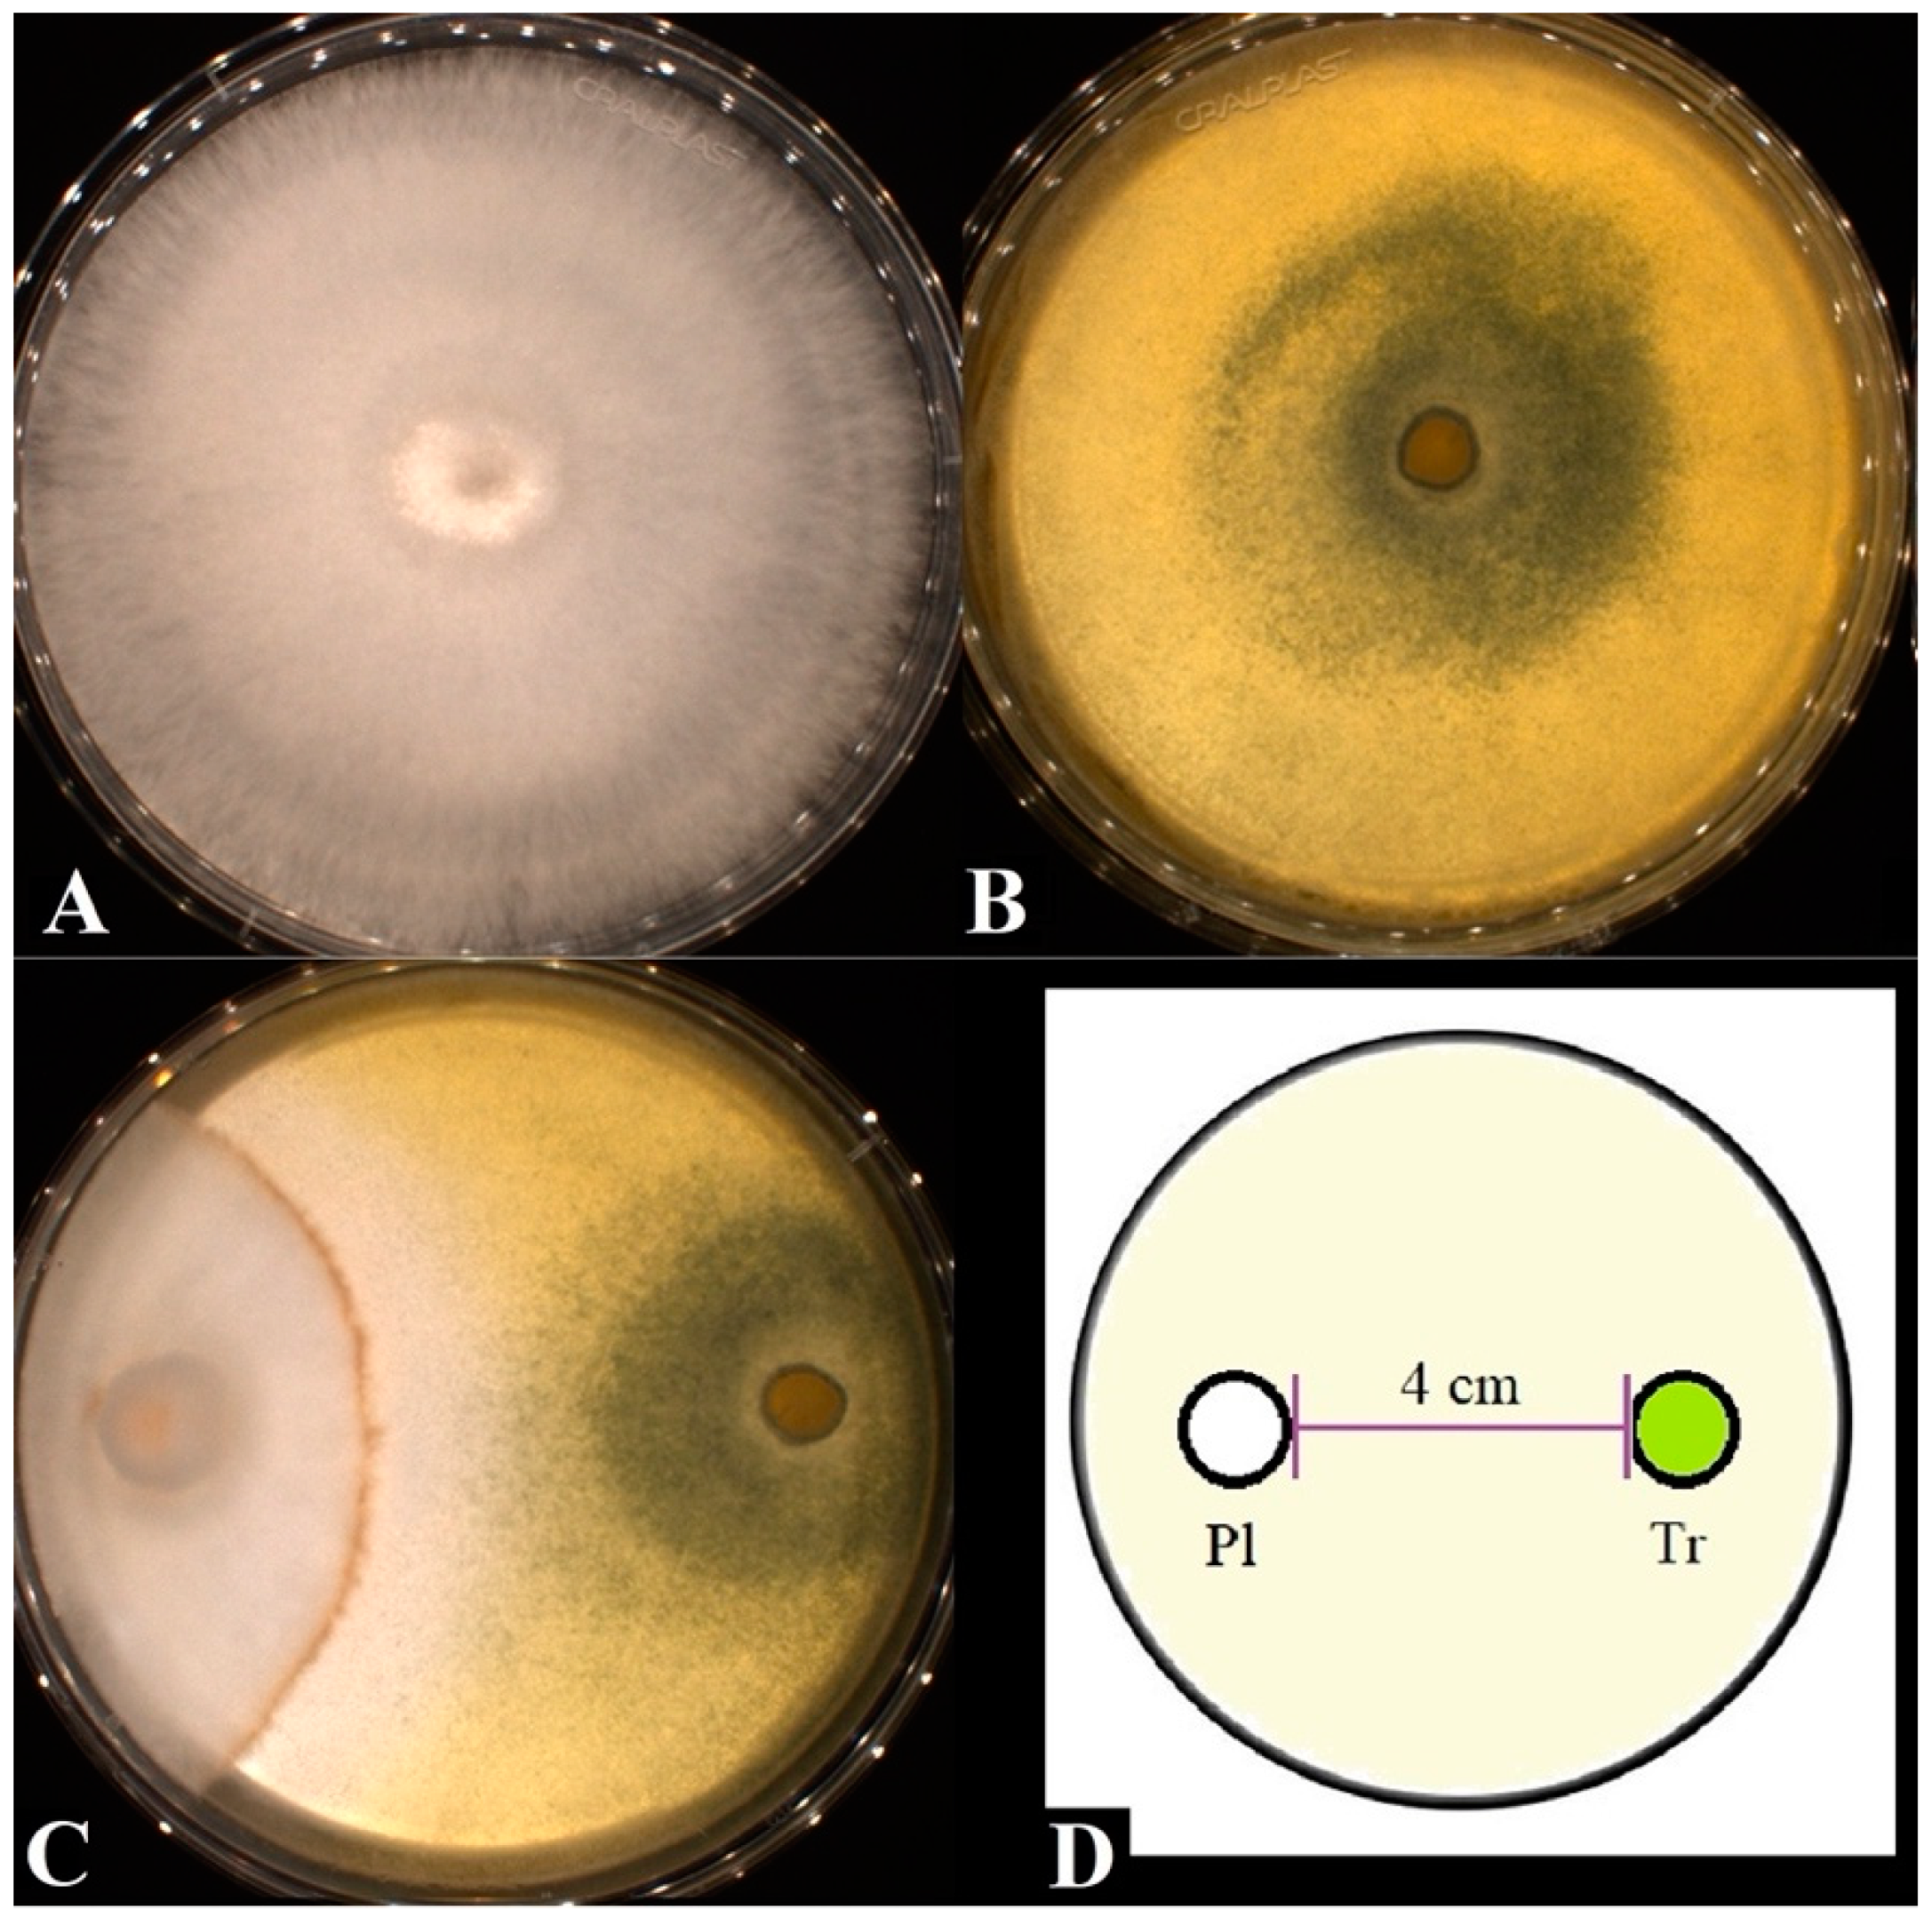
Fermentation 08 00522 g001 Fermentation 08 00522 g001

Production of Enzymatic Extract with High Cellulolytic and Oxidative Activities by Co-Culture of Trichoderma reesei and Panus lecomtei
Abstract
1. Introduction
2. Materials and Methods
2.1. Biomass and Fungi Strains
2.2. Growth Interaction on Solid Media
2.3. Selection of Temperature and Inoculum Time Interval for Tr and Pl Co-Cultures
2.4. Selection of Media Composition for Enzyme Production in Submerged Fermentation
2.5. Enzyme Extract Obtention and Activity Assays
2.6. Hydrolytic Performance of Enzymatic Extracts
2.7. Fermentation of Hydrolysates by S. cerevisiae
2.8. Analytical Methods
3. Results and Discussion
3.1. Growth Interaction of Tr and Pl
3.2. Selection of Temperature and Inoculum Interval of Tr and Pl in Co-Cultures
3.3. Hydrolysis of Pretreated Sugarcane Bagasse Using Enzyme Extracts from Co-Cultures and Monocultures of Tr and Pl
3.4. Culture Media for the Production of Lignocellulolytic Enzymes by Co-Cultures of Tr and Pl
3.5. Hydrolysis of Pretreated Sugarcane Bagasse Using Crude Enzyme Extracts from Cultures Subjected to Variation in Medium Composition
3.6. Fermentative Profile of Ethanol Production by S. cerevisiae from Hydrolysates of Pretreated Sugarcane Biomass
4. Conclusions
Author Contributions
Funding
Institutional Review Board Statement
Informed Consent Statement
Data Availability Statement
Acknowledgments
Conflicts of Interest
References
- Haghighi Mood, S.; Hossein Golfeshan, A.; Tabatabaei, M.; Salehi Jouzani, G.; Najafi, G.H.; Gholami, M.; Ardjmand, M. Lignocellulosic Biomass to Bioethanol, a Comprehensive Review with a Focus on Pretreatment. Renew. Sustain. Energy Rev. 2013, 27, 77–93. [Google Scholar] [CrossRef]
- Almeida, J.R.M.; Modig, T.; Petersson, A.; Hähn-Hägerdal, B.; Lidén, G.; Gorwa-Grauslund, M.F. Increased Tolerance and Conversion of Inhibitors in Lignocellulosic Hydrolysates by Saccharomyces Cerevisiae. J. Chem. Technol. Biotechnol. 2007, 82, 340–349. [Google Scholar] [CrossRef]
- Palmqvist, E.; Hahn-Hägerdal, B.; Szengyel, Z.; Zacchi, G.; Rèczey, K. Simultaneous Detoxification and Enzyme Production of Hemicellulose Hydrolysates Obtained after Steam Pretreatment. Enzym. Microb. Technol. 1997, 20, 286–293. [Google Scholar] [CrossRef]
- Jönsson, L.J.; Palmqvist, E.; Nilvebrant, N.O.; Hahn-Hägerdal, B. Detoxification of Wood Hydrolysates with Laccase and Peroxidase from the White-Rot Fungus Trametes Versicolor. Appl. Microbiol. Biotechnol. 1998, 49, 691–697. [Google Scholar] [CrossRef]
- Sperandio, G.B.; Ferreira Filho, E.X. Fungal Co-Cultures in the Lignocellulosic Biorefinery Context: A Review. Int. Biodeterior. Biodegrad. 2019, 142, 109–123. [Google Scholar] [CrossRef]
- Li, P.; Wang, H.; Liu, G.; Li, X.; Yao, J. The Effect of Carbon Source Succession on Laccase Activity in the Co-Culture Process of Ganoderma Lucidum and a Yeast. Enzym. Microb. Technol. 2011, 48, 1–6. [Google Scholar] [CrossRef] [PubMed]
- Sanitá Lima, M.; Coutinho de Lucas, R. Co-Cultivation, Co-Culture, Mixed Culture, and Microbial Consortium of Fungi: An Understudied Strategy for Biomass Conversion. Front. Microbiol. 2022, 12, 1–4. [Google Scholar] [CrossRef] [PubMed]
- Romero-Peláez, R.D.; Wischral, D.; Mendes, T.D.; Pacheco, T.F.; Urben, A.F.; Helm, C.V.; Mendonça, S.; Balan, V.; de Siqueira, F.G. Co-Culturing of Micro- and Macro-Fungi for Producing Highly Active Enzyme Cocktail for Producing Biofuels. Bioresour. Technol. Rep. 2021, 16, 100833. [Google Scholar] [CrossRef]
- Molla, A.H.; Fakhru’l-Razi, A.; Abd-Aziz, S.; Hanafi, M.M.; Alam, M.Z. In-Vitro Compatibility Evaluation of Fungal Mixed Culture for Bioconversion of Domestic Wastewater Sludge. World J. Microbiol. Biotechnol. 2001, 17, 849–856. [Google Scholar] [CrossRef]
- Noor Mohammad Development of Compatible Fungal Mixed Culture for Composting Process of Oil Palm Industrial Waste. Afr. J. Biotechnol. 2011, 10, 18657–18665. [CrossRef]
- Mandels, M.; Weber, J. The Production of Cellulases. In Cellulases and Their Applications; American Chemical Society: Washington, DC, USA, 1969; Volume 95, pp. 23–391. [Google Scholar]
- Ghose, T.K. Measurement of Cellulase Activities. Pure Appl. Chem. 1987, 59, 257–268. [Google Scholar] [CrossRef]
- Miller, G.L. Use of Dinitrosalicylic Acid Reagent for Determination of Reducing Sugar. Anal. Chem. 1959, 31, 426–428. [Google Scholar] [CrossRef]
- Heinzkill, M.; Bech, L.; Halkier, T.; Schneider, P.; Anke, T. Characterization of Laccases and Peroxidases from Wood-Rotting Fungi (Family Coprinaceae). Appl. Environ. Microbiol. 1998, 64, 1601–1606. [Google Scholar] [CrossRef]
- Wolfenden, B.S.; Willson, R.L. Radical-Cations as Reference Chromogens in Kinetic Studies of Ono-Electron Transfer Reactions: Pulse Radiolysis Studies of 2,2′-Azinobis-(3-Ethylbenzthiazoline-6-Sulphonate). J. Chem. Soc. Perkin Trans. 2 2004, 2, 805–812. [Google Scholar] [CrossRef]
- Soni, S.K.; Batra, N.; Bansal, N.; Soni, R. Bioconversion of Sugarcane Bagasse into Second Generation Bioethanol after Enzymatic Hydrolysis with in-House Produced Cellulases from Aspergillus Sp. S4B2F. BioResources 2010, 5, 741–757. [Google Scholar] [CrossRef]
- Sluiter, A.; Hyman, D.; Payne, C.; Wolfe, J.; Hames, B.; Hyman, D.; Payne, C.; Ruiz, R.; Scarlata, C.; Sluiter, J.; et al. Determination of Structural Carbohydrates and Lignin in Biomass Determination of Structural Carbohydrates and Lignin in Biomass. Natl. Renew. Energy Lab. 2008, 2011, 1–9. [Google Scholar]
- Boddy, L.; Hiscox, J. Fungal Ecology: Principles and Mechanisms of Colonization and Competition by Saprotrophic Fungi. Microbiol. Spectr. 2017, 4, 1–16. [Google Scholar] [CrossRef]
- Evans, J.A.; Eyre, C.A.; Rogers, H.J.; Boddy, L.; Müller, C.T. Changes in Volatile Production during Interspecific Interactions between Four Wood Rotting Fungi Growing in Artificial Media. Fungal Ecol. 2008, 1, 57–68. [Google Scholar] [CrossRef]
- Savoie, J.M.; Mata, G.; Mamoun, M. Variability in Brown Line Formation and Extracellular Laccase Production during Interaction between White-Rot Basidiomycetes and Trichoderma harzianum Biotype Th2. Mycologia 2001, 93, 243–248. [Google Scholar] [CrossRef]
- Sista Kameshwar, A.K.; Qin, W. Comparative Study of Genome-Wide Plant Biomass-Degrading CAZymes in White Rot, Brown Rot and Soft Rot Fungi. Mycologia 2018, 9, 93–105. [Google Scholar] [CrossRef] [PubMed]
- Mathew, G.M.; Sukumaran, R.K.; Singhania, R.R.; Pandey, A. Progress in Research on Fungal Cellulases for Lignocellulose Degradation. J. Sci. Ind. Res. 2008, 67, 898–907. [Google Scholar]
- Bonnarme, P.; Perez, J.; Jeffries, T.W. Regulation of Ligninase Production in White-Rot Fungi. In Enzymes in Biomass Conversion; American Chemical Society: Washington, DC, USA, 1991; pp. 200–206. [Google Scholar]
- De Oliveira Rodrigues, P.; Gurgel, L.V.A.; Pasquini, D.; Badotti, F.; Góes-Neto, A.; Baffi, M.A. Lignocellulose-Degrading Enzymes Production by Solid-State Fermentation through Fungal Consortium among Ascomycetes and Basidiomycetes. Renew. Energy 2020, 145, 2683–2693. [Google Scholar] [CrossRef]
- Šnajdr, J.; Baldrian, P. Temperature Affects the Production, Activity and Stability of Ligninolytic Enzymes in Pleurotus Ostreatus and Trametes Versicolor. Folia Microbiol. 2007, 52, 498–502. [Google Scholar] [CrossRef] [PubMed]
- Kalyani, D.; Lee, K.M.; Kim, T.S.; Li, J.; Dhiman, S.S.; Kang, Y.C.; Lee, J.K. Microbial Consortia for Saccharification of Woody Biomass and Ethanol Fermentation. Fuel 2013, 107, 815–822. [Google Scholar] [CrossRef]
- Metreveli, E.; Kachlishvili, E.; Singer, S.W.; Elisashvili, V. Alteration of White-Rot Basidiomycetes Cellulase and Xylanase Activities in the Submerged Co-Cultivation and Optimization of Enzyme Production by Irpex Lacteus and Schizophyllum Commune. Bioresour. Technol. 2017, 241, 652–660. [Google Scholar] [CrossRef] [PubMed]
- Rehman, S.; Aslam, H.; Ahmad, A.; Ahmed Khan, S.; Sohail, M. Production of Plant Cell Wall Degrading Enzymes by Monoculture and Co-Culture of Aspergillus Niger and Aspergillus Terreus under SSF of Banana Peels. Braz. J. Microbiol. 2014, 45, 1485–1492. [Google Scholar] [CrossRef] [PubMed]
- Chen, K.J.; Tang, J.C.; Xu, B.H.; Lan, S.L.; Cao, Y. Degradation Enhancement of Rice Straw by Co-Culture of Phanerochaete Chrysosporium and Trichoderma Viride. Sci. Rep. 2019, 9, 19708. [Google Scholar] [CrossRef]
- Zhao, B.; Al Rasheed, H.; Ali, I.; Hu, S. Efficient Enzymatic Saccharification of Alkaline and Ionic Liquid-Pretreated Bamboo by Highly Active Extremozymes Produced by the Co-Culture of Two Halophilic Fungi. Bioresour. Technol. 2021, 319, 124115. [Google Scholar] [CrossRef]
- Thamvithayakorn, P.; Phosri, C.; Pisutpaisal, N.; Krajangsang, S.; Whalley, A.J.S.; Suwannasai, N. Utilization of Oil Palm Decanter Cake for Valuable Laccase and Manganese Peroxidase Enzyme Production from a Novel White-Rot Fungus, Pseudolagarobasidium Sp. PP17-33. 3 Biotech. 2019, 9, 417. [Google Scholar] [CrossRef]
- Do-Myoung, K.; Eun, J.C.; Ji, W.K.; Yong-Woog, L.; Hwa-Jee, C. Production of Cellulases by Penicillium Sp. in a Solid-State Fermentation of Oil Palm Empty Fruit Bunch. Afr. J. Biotechnol. 2014, 13, 145–155. [Google Scholar] [CrossRef]
- Brar, K.K.; Espirito Santo, M.C.; Pellegrini, V.O.A.; DeAzevedo, E.R.; Guimaraes, F.E.C.; Polikarpov, I.; Chadha, B.S. Enhanced Hydrolysis of Hydrothermally and Autohydrolytically Treated Sugarcane Bagasse and Understanding the Structural Changes Leading to Improved Saccharification. Biom. Bioener. 2020, 139, 105639. [Google Scholar] [CrossRef]
- Visser, E.M.; Leal, T.F.; de Almeida, M.N.; Guimarães, V.M. Increased Enzymatic Hydrolysis of Sugarcane Bagasse from Enzyme Recycling. Biotechnol. Biof. 2015, 8, 1–9. [Google Scholar] [CrossRef]
- Palonen, H.; Viikari, L. Role of Oxidative Enzymatic Treatments on Enzymatic Hydrolysis of Softwood. Biotechnol. Bioeng. 2004, 86, 550–557. [Google Scholar] [CrossRef]
- Chablé-Villacis, R.; Olguin-Maciel, E.; Toledano-Thompson, T.; Alzate-Gaviria, L.; Ruiz, H.A.; Tapia-Tussell, R. Enzymatic Hydrolysis Assisted with Ligninocellulolytic Enzymes from Trametes Hirsuta Produced by Pineapple Leaf Waste Bioconversion in Solid-State Fermentation. Biomass Convers. Biorefinery 2021, 1–12. [Google Scholar] [CrossRef]
- Rocha-Martín, J.; Martínez-Bernal, C.; Zamorano, L.S.; Reyes-Sosa, F.M.; Díez García, B. Inhibition of Enzymatic Hydrolysis of Pretreated Corn Stover and Sugar Cane Straw by Laccases. Process Biochem. 2018, 67, 88–91. [Google Scholar] [CrossRef]
- Broeker, J.; Mechelke, M.; Baudrexl, M.; Mennerich, D.; Hornburg, D.; Mann, M.; Schwarz, W.H.; Liebl, W.; Zverlov, V.V. The Hemicellulose-Degrading Enzyme System of the Thermophilic Bacterium Clostridium Stercorarium: Comparative Characterisation and Addition of New Hemicellulolytic Glycoside Hydrolases. Biotechnol. Biof. 2018, 11, 229. [Google Scholar] [CrossRef]
- Yoshida, M.; Liu, Y.; Uchida, S.; Kawarada, K.; Ukagami, Y.; Ichinose, H.; Kaneko, S.; Fukuda, K. Effects of Cellulose Crystallinity, Hemicellulose, and Lignin on the Enzymatic Hydrolysis of Miscanthus Sinensis to Monosaccharides. Biosci. Biotechnol. Biochem. 2008, 72, 805–810. [Google Scholar] [CrossRef]
- Wang, R.; You, T.; Yang, G.; Xu, F. Efficient Short Time White Rot-Brown Rot Fungal Pretreatments for the Enhancement of Enzymatic Saccharification of Corn Cobs. ACS Sustain. Chem. Eng. 2017, 5, 10849–10857. [Google Scholar] [CrossRef]
- Bergmann, J.C.; Trichez, D.; de Morais Junior, W.G.; Ramos, T.G.S.; Pacheco, T.F.; Carneiro, C.V.G.C.; Honorato, V.M.; Serra, L.A.; Almeida, J.R.M. Biotechnological Application of Non-Conventional Yeasts for Xylose Valorization. In Non-Conventional Yeasts: From Basic Research to Application; Springer: Cham, Switzerland, 2019; pp. 23–74. ISBN 9783030211103. [Google Scholar]
- Ramos, T.G.S.; Justen, F.; Carneiro, C.V.G.C.; Honorato, V.M.; Franco, P.F.; Vieira, F.S.; Trichez, D.; Rodrigues, C.M.; Almeida, J.R.M. Xylonic Acid Production by Recombinant Komagataella Phaffii Strains Engineered with Newly Identified Xylose Dehydrogenases. Bioresour. Technol. Rep. 2021, 16, 100825. [Google Scholar] [CrossRef]
- Carneiro, C.V.G.C.; de Paula E Silva, F.C.; Almeida, J.R.M. Xylitol Production: Identification and Comparison of New Producing Yeasts. Microorganisms 2019, 7, 484. [Google Scholar] [CrossRef]
- Veras, H.C.T.; Campos, C.G.; Nascimento, I.F.; Abdelnur, P.V.; Almeida, J.R.M.; Parachin, N.S. Metabolic Flux Analysis for Metabolome Data Validation of Naturally Xylose-Fermenting Yeasts. BMC Biotechnol. 2019, 19, 58. [Google Scholar] [CrossRef] [PubMed]
- Soares, C.E.V.F.; Bergmann, J.C.; de Almeida, J.R.M. Variable and Dose-Dependent Response of Saccharomyces and Non-Saccharomyces Yeasts toward Lignocellulosic Hydrolysate Inhibitors. Braz. J. Microbiol. 2021, 52, 575–586. [Google Scholar] [CrossRef] [PubMed]
- Moysés, D.N.; Reis, V.C.B.; de Almeida, J.R.M.; de Moraes, L.M.P.; Torres, F.A.G. Xylose Fermentation by Saccharomyces Cerevisiae: Challenges and prospects. Int. J. Mol. Sci. 2016, 17, 207. [Google Scholar] [CrossRef] [PubMed]
- Jurado, M.; Prieto, A.; Martínez-Alcalá, Á.; Martínez, Á.T.; Martínez, M.J. Laccase Detoxification of Steam-Exploded Wheat Straw for Second Generation Bioethanol. Bioresour. Technol. 2009, 100, 6378–6384. [Google Scholar] [CrossRef] [PubMed]

| Component | Initial Medium (IM) | M1 | M2 | M3 | M4 | M5 | Unit |
|---|---|---|---|---|---|---|---|
| Urea | 0.30 | 0.45 | 0.45 | 0.15 | 0.45 | 0.15 | g/L |
| Yeast extract | 0.75 | 1.13 | 0.38 | 0.38 | 0.75 | 1.13 | g/L |
| Bacteriological peptone | 0.25 | 0.13 | 0.13 | 0.13 | 0.13 | 0.13 | g/L |
| (NH4)2SO4 | 1.40 | 2.10 | 2.10 | 2.10 | 2.10 | 0.70 | g/L |
| KH2PO4 | 2.00 | 3.00 | 3.00 | 1.00 | 2.00 | 3.00 | g/L |
| CaCl2 | 0.40 | 0.20 | 0.20 | 0.20 | 0.20 | 0.60 | g/L |
| MgSO4·7H2O | 0.30 | 0.45 | 0.45 | 0.15 | 0.45 | 0.15 | g/L |
| CuSO4·5H2O | 0.00 | 0.43 | 0.43 | 0.43 | 0.43 | 0.43 | g/L |
| ZnSO4·7H2O | 1.40 | 2.80 | 0.00 | 0.00 | 1.40 | 2.80 | mg/L |
| CoCl2·6H2O | 2.00 | 0.00 | 0.00 | 0.00 | 0.00 | 4.00 | mg/L |
| MnSO4·H2O | 1.04 | 0.00 | 2.08 | 2.08 | 1.04 | 0.00 | mg/L |
| FeSO4·7H2O | 5.00 | 10.00 | 0.00 | 10.00 | 0.00 | 10.00 | mg/L |
| Oil palm decanter cake (OPDC) | 25.00 | 0.00 | 0.00 | 50.00 | 25.00 | 0.00 | g/L |
| Cottonseed cake (CSC) | 0.00 | 0.00 | 50.00 | 50.00 | 50.00 | 50.00 | g/L |
| Wheat bran (WB) | 0.00 | 20.00 | 20.00 | 20.00 | 20.00 | 20.00 | g/L |
| Extract Production Temperature | Culture | Inoculum Interval | FPU/g ** | Glucose (g/L) | HE (%) * |
|---|---|---|---|---|---|
| 25 °C | PlTr | 24 h | 18.79 | 9.36 ± 0.48 b | 44.74 ± 2.27 b |
| 48 h | 17.09 | 8.61 ± 0.37c | 41.15 ± 1.78 c | ||
| 72 h | 14.53 | 8.26 ± 0.60 c | 39.51 ± 2.86 c | ||
| Pl | - | 2.69 | 0.44 ± 0.04 g | 2.09 ± 0.21 g | |
| Tr | - | 20.66 | 6.00 ± 0.21 de | 28.72 ± 1.01 de | |
| 28 °C | PlTr | 24 h | 16.53 | 8.36 ± 0.54 c | 39.99 ± 2.56 c |
| 48 h | 13.13 | 6.54 ± 0.48 d | 31.27 ± 2.28 d | ||
| 72 h | 14.05 | 6.30 ± 0.63 de | 30.11 ± 3.03 de | ||
| Pl | - | 2.06 | 0.44 ± 0.04 g | 2.10 ± 0.20 g | |
| Tr | - | 13.79 | 8.28 ± 0.58 c | 39.61 ± 2.76 c | |
| 31 °C | PlTr | 24 h | 30.94 | 5.64 ± 0.56 e | 26.97 ± 2.68 e |
| 48 h | 22.31 | 4.12 ± 0.24 f | 19.68 ± 1.13 f | ||
| 72 h | 21.30 | 4.20 ± 0.42 f | 20.11 ± 1.99 f | ||
| Pl | - | 2.65 | 0.42 ± 0.03 g | 2.02 ± 0.17 g | |
| Tr | - | 25.4 | 5.83 ± 0.33 e | 27.86 ± 1.57 e | |
| Cellic Ctec 3 | 15.00 | 16.80 ± 0.48 a | 79.80 ± 2.30 a | ||
| Culture Medium | Enzyme Extract | ** FPU/g | Glucose (g/L) | * HE (%) | Xylose (g/L) | * HE (%) | Total HE (%) |
|---|---|---|---|---|---|---|---|
| M1 | PlTr | 25.21 | 9.61 ± 1.19 d | 45.84 ± 0.05 d | 5.53 ± 0.45 b | 62.43 ± 5.03 b | 50.87 |
| Pl | 0.65 | 0.77 ± 0.09 h | 3.64 ± 0.42 h | 0.00 ± 0.00 f | 0.00 ± 0.00 f | 2.57 | |
| Tr | 29.16 | 9.90 ± 0.61 d | 47.17 ± 2.90 d | 0.80 ± 0.11 d | 9.05 ± 1.20 d | 35.96 | |
| M2 | PlTr | 11.92 | 9.20 ± 0.01 d | 43.84 ± 0.05 d | 6.21 ± 0.87 ab | 70.14 ± 9.78 ab | 51.79 |
| Pl | 1.17 | 0.82 ± 0.10 h | 3.93 ± 0.49 h | 0.46 ± 0.10 ef | 5.18 ± 1.09 ef | 4.31 | |
| Tr | 3.12 | 6.74 ± 0.72 e | 32.11 ± 3.45 e | 0.73 ± 0.12 ef | 8.29 ± 1.35 ef | 25.11 | |
| M3 | PlTr | 1.54 | 1.26 ± 0.01 gh | 6.00 ± 0.05 gh | 3.81 ± 0.11 c | 43.04 ± 1.27 c | 17.04 |
| Pl | 1.00 | 2.39 ± 0.11 g | 11.39 ± 0.54 g | 0.09 ± 0.06 ef | 0.99 ± 0.73 ef | 8.33 | |
| Tr | 1.02 | 4.56 ± 0.59 f | 21.73 ± 2.82 f | 0.15 ± 0.00 ef | 1.74 ± 0.00 ef | 15.85 | |
| M4 | PlTr | 14.47 | 14.24 ± 0.20 b | 67.86 ± 0.96 b | 5.44 ± 0.11 b | 61.44 ± 1.22 b | 66.14 |
| Pl | 1.39 | 0.78 ± 0.03 h | 3.74 ± 0.15 h | 0.29 ± 0.12 ef | 3.29 ± 1.35 ef | 3.61 | |
| Tr | 1.52 | 4.72 ± 1.01 f | 22.48 ± 1.01 f | 0.13 ± 0.09 ef | 1.50 ± 1.03 ef | 16.30 | |
| M5 | PlTr | 26.71 | 11.64 ± 0.05 c | 55.48 ± 0.26 c | 6.42 ± 0.09 a | 72.53 ± 0.99 a | 60.71 |
| Pl | 1.04 | 0.72 ± 0.04 h | 3.44 ± 0.18 h | 0.19 ± 0.08 ef | 2.14 ± 0.86 ef | 3.07 | |
| Tr | 2.70 | 4.06 ± 0.07 f | 19.34 ± 0.34 f | 0.58 ± 0.20 ef | 6.56 ± 2.31 ef | 15.60 | |
| Cellic Ctec 3 | 15.00 | 16.68 ± 0.45 a | 79.80 ± 2.30 a | 6.06 ± 0.17 ab | 68.48 ± 2.92 ab | 76.43 | |
| Medium | Culture | Glucose (g/L) | Acetic Acid (g/L) | Ethanol (g/L) | Yield (g/g) | Productivity (g/L·h) | Efficiency (%) |
|---|---|---|---|---|---|---|---|
| M1 | PlTr | 8.91 | 1.28 | 3.79 | 0.43 | 0.63 | 79.44 |
| Pl | 8.63 Δ | 0.23 | 0.85 | 0.10 | 0.12 | 17.17 | |
| Tr | 7.83 Δ | 0.46 | 2.36 | 0.30 | 0.34 | 63.99 | |
| M2 | PlTr | 9.61 | 1.46 | 3.99 | 0.41 | 1.00 | 77.66 |
| Pl | 9.56 Δ | 0.26 | 2.03 | 0.21 | 0.29 | 42.50 | |
| Tr | 8.54 Δ | 0.63 | 1.77 | 0.21 | 0.25 | 43.96 | |
| M3 | PlTr | 9.00 Δ | 1.09 | 4.01 | 0.45 | 1.00 | 78.33 |
| Pl | 9.08 Δ | 0.18 | 1.94 | 0.21 | 0.28 | 41.18 | |
| Tr | 8.77 Δ | 0.45 | 2.11 | 0.24 | 0.30 | 51.58 | |
| M4 | PlTr | 13.35 | 1.17 | 5.76 | 0.43 | 1.44 | 79.94 |
| Pl | 7.97 Δ | 0.21 | 1.29 | 0.16 | 0.18 | 32.05 | |
| Tr | 8.57 Δ | 0.38 | 2.58 | 0.30 | 0.37 | 58.81 | |
| M5 | PlTr | 11.59 | 1.29 | 4.74 | 0.41 | 0.79 | 75.57 |
| Pl | 8.34 Δ | 0.16 | 1.47 | 0.18 | 0.21 | 49.97 | |
| Tr | 12.40 Δ | 0.49 | 0.82 | 0.07 | 0.12 | 25.69 |
Publisher’s Note: MDPI stays neutral with regard to jurisdictional claims in published maps and institutional affiliations. |
© 2022 by the authors. Licensee MDPI, Basel, Switzerland. This article is an open access article distributed under the terms and conditions of the Creative Commons Attribution (CC BY) license (https://creativecommons.org/licenses/by/4.0/).
Share and Cite
Peláez, R.D.R.; Wischral, D.; Cunha, J.R.B.; Mendes, T.D.; Pacheco, T.F.; Siqueira, F.G.d.; Almeida, J.R.M.d. Production of Enzymatic Extract with High Cellulolytic and Oxidative Activities by Co-Culture of Trichoderma reesei and Panus lecomtei. Fermentation 2022, 8, 522. https://doi.org/10.3390/fermentation8100522
Peláez RDR, Wischral D, Cunha JRB, Mendes TD, Pacheco TF, Siqueira FGd, Almeida JRMd. Production of Enzymatic Extract with High Cellulolytic and Oxidative Activities by Co-Culture of Trichoderma reesei and Panus lecomtei. Fermentation. 2022; 8(10):522. https://doi.org/10.3390/fermentation8100522
Chicago/Turabian StylePeláez, Rubén Darío Romero, Daiana Wischral, Joice Raísa Barbosa Cunha, Thais Demarchi Mendes, Thályta Fraga Pacheco, Félix Gonçalves de Siqueira, and João Ricardo Moreira de Almeida. 2022. "Production of Enzymatic Extract with High Cellulolytic and Oxidative Activities by Co-Culture of Trichoderma reesei and Panus lecomtei" Fermentation 8, no. 10: 522. https://doi.org/10.3390/fermentation8100522
APA StylePeláez, R. D. R., Wischral, D., Cunha, J. R. B., Mendes, T. D., Pacheco, T. F., Siqueira, F. G. d., & Almeida, J. R. M. d. (2022). Production of Enzymatic Extract with High Cellulolytic and Oxidative Activities by Co-Culture of Trichoderma reesei and Panus lecomtei. Fermentation, 8(10), 522. https://doi.org/10.3390/fermentation8100522

